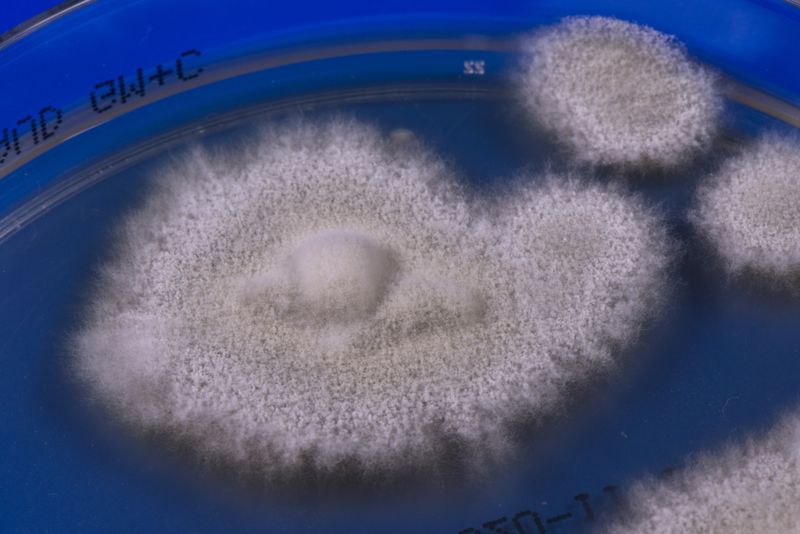

أميركا تُسجّل أوّل إصابتين بمرض معد ومقاوم للأدوية.. ما هو؟
أعلنت المراكز الأميركية لمراقبة الأمراض والوقاية منها، مؤخرا، تسجيل أول إصابتين بمرض جلدي معد للغاية ومقاوم للأدوية، في الولايات المتحدة، فيما يقول الأطباء إن العلاج يستغرق وقتا طويلا.
وبحسب الهيئة الصحية الأميركية، فإنه جرى تشخيص المرض الجلدي لدى سيدتين في ولاية نيويورك.
والمرض الذي جرى رصده يعرف بـ"Trichophyton indotineae"، وهو عبارة عن فطريات مسببة لما يسمى بـ"السعفة" التي تسبب حكة وبثورا واحمرارا للجسد في مختلف مناطق الجسم.
والعدوى من هذه السلالة المضادة للأدوية شائعة في منطقة جنوب آسيا، لكن لم يجر رصدها من قبل في الولايات المتحدة.
وفي الحالتين المسجلتين بنيويورك، وعمرهما 28 و47، أدت العدوى إلى بثور في العنف ومنطقة البطن، بحسب المراكز الأميركية.
وبادر طبيب مختص في الجلد فحص الحالتين، إلى إخطار السلطات في 28 شباط 2023، فيما كانت حالتهما لا تستجيب للعلاج.
وأصيب المريضة الأصغر عمرا في صيف 2021، بينما كانت حاملا، وبدأت العلاج بعد الإنجاب، لكن وضعها لم يتحسن بعد أسبوعين.
وتم إعطاء علاج آخر، من أجل وقف الحكة، وذاك ما حصل، لكن الأطباء ما زالوا يراقبون لمعرفة ما إذا كانت حالتها ستسوء مجددا.
أما المرأة الثانية، فأصيبت بالمرض بعد رحلة إلى إحدى الدول الآسيوية في صيف 2022، وما زالت تأخذ علاجا حتى الآن، ويقدر الأطباء أنها تحسنت بنسبة 80 بالمئة.
وأوضح مسؤولون أميركيون أن السيدتين لا تعرفان بعضهما البعض، كما أن الأولى لم يسبق لها أن سافرت، وبالتالي، فمن المحتمل، أن تكون العدوى قد انتقلت إليها وهي في الولايات المتحدة.
المصدر: سكاي نيوز